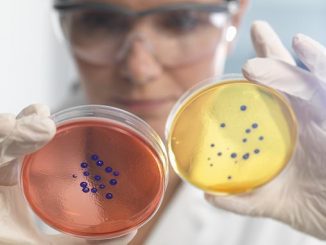

Teen jobs: Some parents cautious about negative impact on grades, sleep and social life
Biggest influencers on parents’ support of teens working Navigating on-the-job conflicts Source: Read Full Article
Biggest influencers on parents’ support of teens working Navigating on-the-job conflicts Source: Read Full Article A major UK study has discovered that the disturbed sleep patterns in patients hospitalized with COVID-19 was likely to be […] Infection with the severe acute respiratory syndrome coronavirus-2 (SARS-CoV-2), which is the causal agent of the ongoing coronavirus disease 2019 […] UK approves first new antibiotic in more than 20 years that kills superbugs, which cause 10,000 UTIs every year, and […] Top Chinese scientist says true source of Covid may never be revealed because research into the origins of the virus […] Integrating buprenorphine and harm eduction tools into primary care may improve clinical outcomes, increase costs only modestly, and be cost […] High fitness levels attenuate, but do not eliminate, the increased risk for cardiovascular mortality in men with high blood pressure, […] Memory impairment associated with steroid use has been identified in a new study. The University of Bristol-led findings, published in […] ChatGPT, an artificial intelligence (AI) chatbot, may be helpful for patients with cirrhosis or hepatocellular carcinoma (HCC) and their clinicians […] A large clinical trial of more than 8,700 patients published in the New England Journal of Medicine concluded that the […]Health News

Teen jobs: Some parents cautious about negative impact on grades, sleep and social life

Disturbed sleep may partially explain long COVID breathlessness

Pregnant women show unique immune response to COVID-19
UK approves first new antibiotic in 20 years to fight UTI superbugs

Top Chinese scientist says true source of Covid may never be revealed

Integrating Addiction Medicine With Primary Care Cost Effective

High fitness level lowers risk for cardiovascular death from high blood pressure

Long-term use of steroids could impair memory, study finds

Harnessing ChatGPT to Improve Liver Disease Outcomes

Sex of blood donor has no effect on recipient survival, finds clinical trial
Copyright © 2026